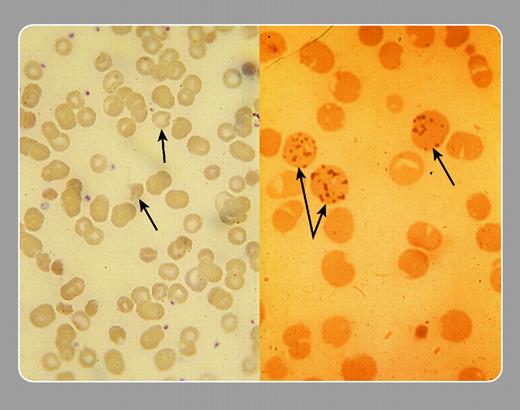
Stanley Schrier, Stanford University Medical Center

The lefthand panel is a peripheral smear from a patient who developed a hemolytic anemia while taking Pyridium (phenazopyridine). She was supposed to take it for 3 days for bladder discomfort but continued taking it for almost a month. Note the “bite cells,” which are abnormal red blood cells (RBCs) that look like a bite has been taken out; other names are hemiblister or cross-linked cells. The drug causes oxidant damage to the RBC membrane and hemoglobin, leading to accelerated removal of the affected RBCs. The righthand panel is a positive Heinz-body preparation from the patient. The supravital stain of the peripheral blood with new methyl violet detects oxidatively denatured hemoglobin. Splenic removal (pitting) of the denatured hemoglobin may produce the “bites” seen in the first panel.
Skip Nav Destination
BLOOD WORK|
November 1, 2003
Citation
Oxidant hemolysis. Blood 2003; 102 (9): 3083. doi: https://doi.org/10.1182/blood.V102.9.3083.3083
Download citation file:
November 1 2003
Advertisement intended for health care professionals
1
Crossref
Cited By
Advertisement intended for health care professionals

Stanley Schrier, Stanford University Medical Center
Stanley Schrier, Stanford University Medical Center
This feature is available to Subscribers Only
Sign In or Create an Account Close Modal